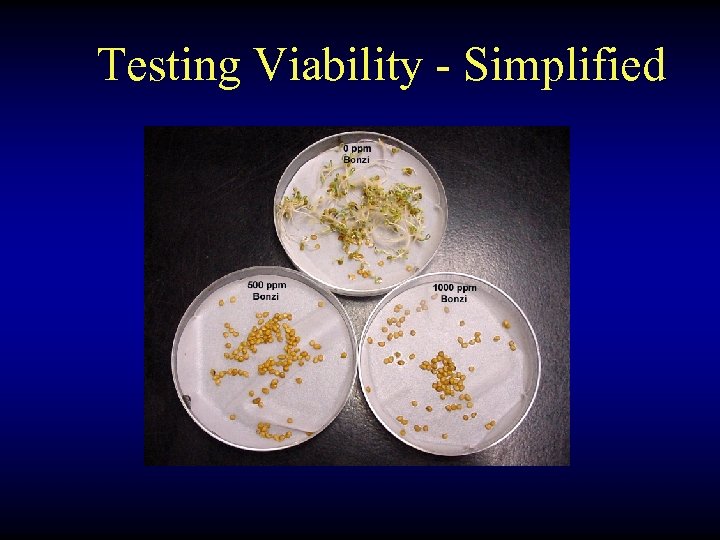

859e30641e299624fd87d57aae826700.ppt
- Количество слайдов: 72
 Producing Plants From Seed Paul A. Thomas The University of Georgia 2012 Seed Germination Workshop Teacher Training Conference
Producing Plants From Seed Paul A. Thomas The University of Georgia 2012 Seed Germination Workshop Teacher Training Conference
 About Seeds
About Seeds
 No Two Seeds Are Alike
No Two Seeds Are Alike
 Three Types Of Seed Sources Fleshy Fruits: Berries, Figs Dry Fruits: Grains, Grasses Dry Seeds / Dehiscent Pods: Cones/Pods
Three Types Of Seed Sources Fleshy Fruits: Berries, Figs Dry Fruits: Grains, Grasses Dry Seeds / Dehiscent Pods: Cones/Pods
 Heritage Heirloom Varieties Vegetables and flowers that were grown and passed on through many generations by families. Seedlings match parent plants closely.
Heritage Heirloom Varieties Vegetables and flowers that were grown and passed on through many generations by families. Seedlings match parent plants closely.
 Terms To Know Landraces – Populations of plants maintained over hundreds of years by farmers by holding over some of the seed crop. This allowed for local specialization and great differences in genetic makeup
Terms To Know Landraces – Populations of plants maintained over hundreds of years by farmers by holding over some of the seed crop. This allowed for local specialization and great differences in genetic makeup
 Terms To Know Cross Pollination – Pollen from one plant fertilizes the embryo sac of another plant within the species. Self Pollination – The pollen from a plant is able to fertilize the embryo sac on the same plant and produce a viable embryo.
Terms To Know Cross Pollination – Pollen from one plant fertilizes the embryo sac of another plant within the species. Self Pollination – The pollen from a plant is able to fertilize the embryo sac on the same plant and produce a viable embryo.
 Seed Collecting Provenance : A seed’s origin, in terms of climate and geographical location. This can Have profound effects on seed germination and the plant’s survival. Example: Hemlocks grown from southern North Carolina seed sources are more heat tolerant than Hemlocks grown from Pennsylvania seed sources.
Seed Collecting Provenance : A seed’s origin, in terms of climate and geographical location. This can Have profound effects on seed germination and the plant’s survival. Example: Hemlocks grown from southern North Carolina seed sources are more heat tolerant than Hemlocks grown from Pennsylvania seed sources.
 Seed Collecting Seeds collected from hybrid vegetables and flowers s rarely look anything like the parent plant due to the random reassortment of genetic material, and the random sources of pollen. Native species tend to be more stable, but also have variation between generations. To get a clone, try vegetative propagation!
Seed Collecting Seeds collected from hybrid vegetables and flowers s rarely look anything like the parent plant due to the random reassortment of genetic material, and the random sources of pollen. Native species tend to be more stable, but also have variation between generations. To get a clone, try vegetative propagation!
 Seed Cleaning / Separation Cleaning seed reduces disease and weed seed from growing along with your selection For many dry seed, simply crush dried material and blow gently, transferring the seed from hand to hand.
Seed Cleaning / Separation Cleaning seed reduces disease and weed seed from growing along with your selection For many dry seed, simply crush dried material and blow gently, transferring the seed from hand to hand.
 Seed Deterioration Seeds lose half their storage life for every 1% increase in seed moisture between 5 and 14%. Seeds lose half their storage life for every 5 degrees C increase in storage o o temperature between 0 and 50 C.
Seed Deterioration Seeds lose half their storage life for every 1% increase in seed moisture between 5 and 14%. Seeds lose half their storage life for every 5 degrees C increase in storage o o temperature between 0 and 50 C.
 Life Expectancy Of Selected Seeds Sugar Maple English Elm Cocklebur White Clover Sensitive Plant Indian Lotus Artic Lupine 2 weeks 26 weeks 16 years 90 years 200 years 1, 040 years 10, 000 years
Life Expectancy Of Selected Seeds Sugar Maple English Elm Cocklebur White Clover Sensitive Plant Indian Lotus Artic Lupine 2 weeks 26 weeks 16 years 90 years 200 years 1, 040 years 10, 000 years
 Terms To Know Recalcitrant Seed – These seeds are able to germinate without dessicating. These seeds lose viability after drying and must be planted quickly. Oak, Maple, Coffee Orthodox Seed – The seeds dessicate after reaching full development to allow the seed to be quiescent or dormant until conditions are right to germinate. Beans
Terms To Know Recalcitrant Seed – These seeds are able to germinate without dessicating. These seeds lose viability after drying and must be planted quickly. Oak, Maple, Coffee Orthodox Seed – The seeds dessicate after reaching full development to allow the seed to be quiescent or dormant until conditions are right to germinate. Beans
 Orthodox Seed Short-Lived – Store dry and cold (Under 1 yr) Vinca, Pansy, Begonia Medium - Lived - Store dry and cold ( 2 -5 years) Marigold, Petunia, Coleus Long - Lived – Store dry and cold ( 5 -200 years) Morning Glory, Zinnia, Hollyhock
Orthodox Seed Short-Lived – Store dry and cold (Under 1 yr) Vinca, Pansy, Begonia Medium - Lived - Store dry and cold ( 2 -5 years) Marigold, Petunia, Coleus Long - Lived – Store dry and cold ( 5 -200 years) Morning Glory, Zinnia, Hollyhock
 SEED STORAGE Recalcitrant Seed – Short-term Viability Tropical – Store warm and moist (ASAP) Coffee, Cocoa, Mango, Macadamia, Avocado, Tea Subtropical – Store cool and moist (ASAP) Maple, Oak, Elm, Poplar, Salix,
SEED STORAGE Recalcitrant Seed – Short-term Viability Tropical – Store warm and moist (ASAP) Coffee, Cocoa, Mango, Macadamia, Avocado, Tea Subtropical – Store cool and moist (ASAP) Maple, Oak, Elm, Poplar, Salix,
 Seed Storage o Moist Storage @35 to 50 F o Dry Storage @ 35 to 50 F* o o Cold Storage @ 0 F, – 18 C * o Cryopreservation @ -196 C * *** at 3 – 8% Moisture
Seed Storage o Moist Storage @35 to 50 F o Dry Storage @ 35 to 50 F* o o Cold Storage @ 0 F, – 18 C * o Cryopreservation @ -196 C * *** at 3 – 8% Moisture
 Important Information Directions Planting Depth Expiration Date Source
Important Information Directions Planting Depth Expiration Date Source
 More Information Lot Number Germination Percentage Scientific Name
More Information Lot Number Germination Percentage Scientific Name
 Seed Coatings • Fungicides/Rhyzobia • Polycoating • Pre-germinated
Seed Coatings • Fungicides/Rhyzobia • Polycoating • Pre-germinated
 Enhanced Seed Park’s Seed
Enhanced Seed Park’s Seed
Testing Viability - Simplified
Testing Viability - Simplified
 The Cycle of Life
The Cycle of Life
 THE GERMINATION PROCESS How Germination Works Water is usually the key factor in starting the germination process.
THE GERMINATION PROCESS How Germination Works Water is usually the key factor in starting the germination process.

 1. Imbibed water stimulates Gibberellin synthesis. 2 -3. Gibberellins diffuse to the aleurone layer and stimulate the synthesis of enzymes. 4 -5. Enzymes break down the starch and the sugars are transported to the developing embryo.
1. Imbibed water stimulates Gibberellin synthesis. 2 -3. Gibberellins diffuse to the aleurone layer and stimulate the synthesis of enzymes. 4 -5. Enzymes break down the starch and the sugars are transported to the developing embryo.
 About Dormancy
About Dormancy
 Seed and Plant Dormancy is the condition In which seeds will not Germinate… even when most of the environmental conditions are permissive for germination. There are many types of dormancy!
Seed and Plant Dormancy is the condition In which seeds will not Germinate… even when most of the environmental conditions are permissive for germination. There are many types of dormancy!
 Advantages of Seed Dormancy • Favors seedling survival • Creates a seed bank • Seed dispersal (birds) • Synchronizes germination with seasons
Advantages of Seed Dormancy • Favors seedling survival • Creates a seed bank • Seed dispersal (birds) • Synchronizes germination with seasons
 Relative Hormone Level Triphasic Changes In Seed Hormone Balance Overwintering of Seeds in the ground (Inhibits) 14 o. C Days of Cold Stratification
Relative Hormone Level Triphasic Changes In Seed Hormone Balance Overwintering of Seeds in the ground (Inhibits) 14 o. C Days of Cold Stratification
 Types of Dormancy in Seed Quiescent – The seeds are able to Germinate upon imbibition of water at permissive temperatures. Primary Dormancy – Seeds cannot germinate even if immediate conditions are right. This form of dormancy delays germination until season, or other macro-environmental issues are right for survival. Secondary Dormancy – An additional level of Protection to prevent germination. Can be induced under very unfavorable conditions such as drought or cold, etc.
Types of Dormancy in Seed Quiescent – The seeds are able to Germinate upon imbibition of water at permissive temperatures. Primary Dormancy – Seeds cannot germinate even if immediate conditions are right. This form of dormancy delays germination until season, or other macro-environmental issues are right for survival. Secondary Dormancy – An additional level of Protection to prevent germination. Can be induced under very unfavorable conditions such as drought or cold, etc.
 Types of Dormancy in Seed Exogenous Dormancy - Imposed by factors outside the embryo. Seed coat. Endogenous Dormancy – Imposed by factors within the embryo. Underdeveloped embryo.
Types of Dormancy in Seed Exogenous Dormancy - Imposed by factors outside the embryo. Seed coat. Endogenous Dormancy – Imposed by factors within the embryo. Underdeveloped embryo.
 Exogenous Dormancy • Physical – Impermeable seed coat : Scarification • Mechanical – Seed covering restricts radical : Removal • Chemical – Inhibitors in seed coat : Removal / Leaching
Exogenous Dormancy • Physical – Impermeable seed coat : Scarification • Mechanical – Seed covering restricts radical : Removal • Chemical – Inhibitors in seed coat : Removal / Leaching
 Endogenous Dormancy Morphological - Underdeveloped embryo : Warm Stratification Physiological • Non-Deep – After Ripening : Dry storage Photo-dormant : Exposure to red light. • Intermediate – Embryo/coat separation : Cold Stratification • Epicotyl – Epicotyl dormant : Warm - Cold Stratification
Endogenous Dormancy Morphological - Underdeveloped embryo : Warm Stratification Physiological • Non-Deep – After Ripening : Dry storage Photo-dormant : Exposure to red light. • Intermediate – Embryo/coat separation : Cold Stratification • Epicotyl – Epicotyl dormant : Warm - Cold Stratification
 Types of Dormancy in Seed Double Dormancy - Any combination of endogenous and exogenous factors Secondary Dormancy - Factors outside the seed induce dormancy after the seed was previously non-dormant. High Soil Temperatures (Thermo-dormancy)
Types of Dormancy in Seed Double Dormancy - Any combination of endogenous and exogenous factors Secondary Dormancy - Factors outside the seed induce dormancy after the seed was previously non-dormant. High Soil Temperatures (Thermo-dormancy)
 Double Dormancy Morpho-physiological – Some combination of underdeveloped embryo and physiological dormancy: Cycles of warm and cold stratification. Exo-Endodormancy – Combination of exogenous and endogenous dormancy conditions Sequential combinations of dormancy releasing treatments, Eg. Scarification followed by cold stratification
Double Dormancy Morpho-physiological – Some combination of underdeveloped embryo and physiological dormancy: Cycles of warm and cold stratification. Exo-Endodormancy – Combination of exogenous and endogenous dormancy conditions Sequential combinations of dormancy releasing treatments, Eg. Scarification followed by cold stratification
 Secondary Dormancy • Thermo-dormancy - High temperatures induce dormancy Growth regulators or Cold stratification • Conditional – Change in ability to germinate is related to time of year. Chilling or Warm stratification
Secondary Dormancy • Thermo-dormancy - High temperatures induce dormancy Growth regulators or Cold stratification • Conditional – Change in ability to germinate is related to time of year. Chilling or Warm stratification
 Photodormancy : A type of dormancy where the ability of the seed to germinate is controlled by the wavelengths and durations of light received by the embryo. Lettuce, Butterflyweed, Tobacco
Photodormancy : A type of dormancy where the ability of the seed to germinate is controlled by the wavelengths and durations of light received by the embryo. Lettuce, Butterflyweed, Tobacco
 Types Of Photoperiodic Response Whereas many plants are photoperiodic, they do not all respond the same way. Short Day Plants – Single Cycle………. Rice Requires only one short day cycle to initiate the photoperiodic response. Long Day Plants – Single Cycle…………. Dill Requires only one long day cycle to initiate the photoperiodic response. Day Neutral Plants………………Cucumber Flower the same time under all day-lengths, least photoperiodic response.
Types Of Photoperiodic Response Whereas many plants are photoperiodic, they do not all respond the same way. Short Day Plants – Single Cycle………. Rice Requires only one short day cycle to initiate the photoperiodic response. Long Day Plants – Single Cycle…………. Dill Requires only one long day cycle to initiate the photoperiodic response. Day Neutral Plants………………Cucumber Flower the same time under all day-lengths, least photoperiodic response.
 Bright Sun 660 nm 740 nm Pr Red Light (Fast) Far Red Light Pfr Dark Reversion Quiescence (Slow) Germination Long hours of bright spring sun stimulates formation of Pfr and germination begins!
Bright Sun 660 nm 740 nm Pr Red Light (Fast) Far Red Light Pfr Dark Reversion Quiescence (Slow) Germination Long hours of bright spring sun stimulates formation of Pfr and germination begins!
 Far Red Light 660 nm 740 nm Pr Red Light (Fast) Far Red Light Pfr Dark Reversion Quiescence (Slow) Germination Far-red light, such as is found under lots of vegetation, prevents germination. Seeds wait for sun!
Far Red Light 660 nm 740 nm Pr Red Light (Fast) Far Red Light Pfr Dark Reversion Quiescence (Slow) Germination Far-red light, such as is found under lots of vegetation, prevents germination. Seeds wait for sun!
 660 nm Pr Red Light (Fast) Far Red Light Dark Reversion Quiescence (Slow) 740 nm Pfr Darkness Germination Darkness maintains Pr and quiescence. Buried seed won’t germinate until brought to the surface!
660 nm Pr Red Light (Fast) Far Red Light Dark Reversion Quiescence (Slow) 740 nm Pfr Darkness Germination Darkness maintains Pr and quiescence. Buried seed won’t germinate until brought to the surface!
 Techniques
Techniques
 Germination Environment Moisture / Humidity Temperature Range Light Level and Quality Aeration (Oxygen in Soil) Soil p. H and Nutrition Air Movement
Germination Environment Moisture / Humidity Temperature Range Light Level and Quality Aeration (Oxygen in Soil) Soil p. H and Nutrition Air Movement
 Technique • • Berry Roll Cracking Scratching Freezing Moist Chilling Hot Soaking Irradiation • You can use a blender!
Technique • • Berry Roll Cracking Scratching Freezing Moist Chilling Hot Soaking Irradiation • You can use a blender!
 Irradiation Germination Of Lettuce
Irradiation Germination Of Lettuce
 Fleshy Berry Seed
Fleshy Berry Seed
 Handling Tiny Seeds Some seeds can be smaller than the tip of a pin. They can also be very expensive. A very careful approach is often needed to be efficient and successful planting tiny seeds
Handling Tiny Seeds Some seeds can be smaller than the tip of a pin. They can also be very expensive. A very careful approach is often needed to be efficient and successful planting tiny seeds
 Handling Tiny Seeds Mix Seed with Sand
Handling Tiny Seeds Mix Seed with Sand
 Preconditioning Seeds (for more uniform germination) Methods: Mechanical scarification Soaking In Water Acid Scarification Moist Chilling / Freezing Double Dormancy
Preconditioning Seeds (for more uniform germination) Methods: Mechanical scarification Soaking In Water Acid Scarification Moist Chilling / Freezing Double Dormancy
 Mechanical Scarification
Mechanical Scarification
 Acid Scarification An alternative to scraping the seed coat is to use acid to etch through the coat. There are many reference books that advise which acid and how long to treat.
Acid Scarification An alternative to scraping the seed coat is to use acid to etch through the coat. There are many reference books that advise which acid and how long to treat.
 Hot Water Scarification Water temperature should be over 110 OF Let soak for a few hours. Stir often. Do not re-heat the water. Plant ASAP.
Hot Water Scarification Water temperature should be over 110 OF Let soak for a few hours. Stir often. Do not re-heat the water. Plant ASAP.
 Seed Soaking / Leaching Seed soaking optimizes the amount of imbibed seeds and evens out the stage of imbibition by insuring 100% moisture availability Soaking too long can cause anoxia and reduced germination. 12 -36 hours is a very common soaking period.
Seed Soaking / Leaching Seed soaking optimizes the amount of imbibed seeds and evens out the stage of imbibition by insuring 100% moisture availability Soaking too long can cause anoxia and reduced germination. 12 -36 hours is a very common soaking period.
 Thermo-hydro-Limitations Time ! • Each species has a requirement for how many hours the seed radical is exposed to a critical level of moisture and/or soil temperature. • Example: Cold, saturated soil inhibits corn seedling radical growth after onset of germination. • Local control: Use a heating pad and well drained soils!
Thermo-hydro-Limitations Time ! • Each species has a requirement for how many hours the seed radical is exposed to a critical level of moisture and/or soil temperature. • Example: Cold, saturated soil inhibits corn seedling radical growth after onset of germination. • Local control: Use a heating pad and well drained soils!
 Moist Stratification Cold or Warm
Moist Stratification Cold or Warm
 Sowing Success • Proper seed bed • Proper planting season • Proper pre-treatment • Proper seed handling • Proper sowing depth • Proper sowing rate • Proper post-sowing care
Sowing Success • Proper seed bed • Proper planting season • Proper pre-treatment • Proper seed handling • Proper sowing depth • Proper sowing rate • Proper post-sowing care
 Seedling Production Options Community Pot Seeding Box Plug Tray Fabric Matt Hydroseeding Direct Broadcast
Seedling Production Options Community Pot Seeding Box Plug Tray Fabric Matt Hydroseeding Direct Broadcast
 Clean & Organized Environment
Clean & Organized Environment
 Fungicides Ban. Rot! Follow The Label Directions!
Fungicides Ban. Rot! Follow The Label Directions!
 Window-Box Propagation Two clear halves of sweater/storage boxes taped together with duct tape as a hinge make ideal propagation boxes! Place the box in a sunny window, and open it up for an hour at night to replace air and dry off leaves. Works for almost all tropical plants.
Window-Box Propagation Two clear halves of sweater/storage boxes taped together with duct tape as a hinge make ideal propagation boxes! Place the box in a sunny window, and open it up for an hour at night to replace air and dry off leaves. Works for almost all tropical plants.
 Germination Chambers
Germination Chambers
 Relative Growth Rate Preferred Night Temperature 15 o. C 30 o. C 10 o. C 22 o. C 14 o. C Degrees Fahrenheit
Relative Growth Rate Preferred Night Temperature 15 o. C 30 o. C 10 o. C 22 o. C 14 o. C Degrees Fahrenheit
 Root Zone Heating Rooting medium temperature, given control, may be applied to speed up growth. A good example is using heating pads under planted seed flats to speed up germination or rooting. The right temperature can take a week or month off of rooting schedule and can take a few days to a few weeks off of germination. Time is money.
Root Zone Heating Rooting medium temperature, given control, may be applied to speed up growth. A good example is using heating pads under planted seed flats to speed up germination or rooting. The right temperature can take a week or month off of rooting schedule and can take a few days to a few weeks off of germination. Time is money.
 Types Of Heating Technology Hot Water Tubes Electric Mats
Types Of Heating Technology Hot Water Tubes Electric Mats
 Electric Heating Tapes
Electric Heating Tapes
 Mist Benches We need to provide seedlings a film of water to reduce evaporation, and the loss of water. Too much water is as bad as too little water!
Mist Benches We need to provide seedlings a film of water to reduce evaporation, and the loss of water. Too much water is as bad as too little water!
 Light Levels Affect Seedlings! As with mature plants, if cuttings are placed in too low light conditions, they will get leggy and may abort leaves. Even if they all live, the final quality of the adult plant is in question. Which plant will be thicker and more branched? Which would you buy?
Light Levels Affect Seedlings! As with mature plants, if cuttings are placed in too low light conditions, they will get leggy and may abort leaves. Even if they all live, the final quality of the adult plant is in question. Which plant will be thicker and more branched? Which would you buy?
 Constantly Wet and/or Stagnant Air Condition Affects Seedlings The leaf surface of seedlings benefits from brief periods of surface dryness, especially at night. Air movement, especially as new root initials form, is essential for root development.
Constantly Wet and/or Stagnant Air Condition Affects Seedlings The leaf surface of seedlings benefits from brief periods of surface dryness, especially at night. Air movement, especially as new root initials form, is essential for root development.
 Experiment One: The Seed Environment A B C Dark Control D E F Vermiculite Extract Light A=Asclepias, B=Catchfly, C=Black Eye, D=Fox. Glove, E=Lettuce, F=Old Seed
Experiment One: The Seed Environment A B C Dark Control D E F Vermiculite Extract Light A=Asclepias, B=Catchfly, C=Black Eye, D=Fox. Glove, E=Lettuce, F=Old Seed
 Experiment Two: Germination Techniques Freeze Pre. Soak Scratch A Crack B C Pre. Soak D sand E F A=Blueberry, B=Pole. Bean, C=Lemon, D=Cherry, E=Fox. Glove, F=Locust
Experiment Two: Germination Techniques Freeze Pre. Soak Scratch A Crack B C Pre. Soak D sand E F A=Blueberry, B=Pole. Bean, C=Lemon, D=Cherry, E=Fox. Glove, F=Locust
 Experiment Three: The Seed Environment Lime Fertilizer D E F Iron Sulfate No Fertilizer A B C Control A=Bean, B=Corn, C=Pumpkin, D=Cosmos, E=Burmuda, F=Marigold
Experiment Three: The Seed Environment Lime Fertilizer D E F Iron Sulfate No Fertilizer A B C Control A=Bean, B=Corn, C=Pumpkin, D=Cosmos, E=Burmuda, F=Marigold
 Gardener by Ann North Some of the seeds of hope Planted tentatively in the fall Have not come up They lie stillborn and unrealized Somewhere in the spring soil Decaying The Strongest and best ones Pushed up though the leaves And layers of cold, hard resistance Right into clear blue air And stand there nakedly green Breathing It's always that way with growing things Never knowing at the start Which will make it and which will fail But the thing to hold fast to Never to lose faith in, is simply, Sowing
Gardener by Ann North Some of the seeds of hope Planted tentatively in the fall Have not come up They lie stillborn and unrealized Somewhere in the spring soil Decaying The Strongest and best ones Pushed up though the leaves And layers of cold, hard resistance Right into clear blue air And stand there nakedly green Breathing It's always that way with growing things Never knowing at the start Which will make it and which will fail But the thing to hold fast to Never to lose faith in, is simply, Sowing


